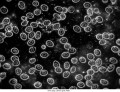
Mikroskop Delta Optical Genetic Pro z kamerą 3MP

Mikroskop Delta Optical Genetic Pro z kamerą 3MP
 Opis
Opis
PROSZĘ, PRZED ZAKUPEM, O SPRAWDZENIE DOSTEPNOSCI PRODUKTU
Mikroskop Delta Optical Genetic Pro to uniwersalne narzędzie, które sprawdzi się w wielu dziedzinach nauki i edukacji. Jest on często wykorzystywany do rutynowych badań przez lekarzy medycyny i weterynarii, w placówkach badań sanitarnych. Delta Optical Genetic Pro można również spotkać w laboratoriach uniwersyteckich, pracowniach studenckich jak i w szkołach ponadgimnazjalnych. Mikroskop ten bywa również częstym wyborem osób, chcących hobbystycznie, ale ambitnie zgłębiać tajniki mikroświata i potrzebujących niezawodnego, dającego duże możliwości pracy sprzętu na lata.
Dlaczego warto wybrać akurat ten model? Ogromną zaletą mikroskopu jest jego stosunek jakości do ceny. Solidna, stabilna i ergonomiczna konstrukcja statywu gwarantuje możliwość jego wieloletniej eksploatacji. Doskonałe, achromatyczne obiektywy pozwalają na uzyskiwanie ostrych obrazów oraz powiększeń w zakresie 40-1000x. Szerokopolowe okulary i jasne oświetlenie LED, dają możliwość oglądania już bardzo niewielkich obiektów. Mechaniczny stolik oraz precyzyjnie regulowane śruby ruchów mikro i makro, zapewniają niezbędną dokładność pracy. Dzięki bogatej ofercie akcesoriów, serię Genetic Pro można rozbudować o inne techniki obserwacji mikroskopowej. Polaryzacja, ciemne pole, kontrast fazowy znacząco zwiększą możliwości tego urządzenia. Szeroka gama kamer mikroskopowych i adapterów fotograficznych pozwoli na dokumentację obrazu w postaci zdjęć i filmów, a bogate w funkcje oprogramowanie na późniejszą analizę i obróbkę tak uzyskanego materiału.
Mikroskopy Delta Optical Genetic Pro oferowane są w szeregu wersji: mono-, bino- i trinokularowej. Dostępne są również modele z własnym, wbudowanym zasilaniem akumulatorowym, pozwalającym na pracę z dala od źródeł prądu.
---
"Mikroskop biologiczny zalecany do użytku szkolnego przez Ministerstwo Edukacji Narodowej, wpisany do wykazu środków dydaktycznych przeznaczonych do kształcenia ogólnego, do nauczania biologii na poziomie gimnazjum, liceum ogólnokształcącego – w zakresie podstawowym i rozszerzonym, liceum profilowanego oraz technikum, na podstawie recenzji rzeczoznawców: - prof. dr hab. Danuty Cichy, zarekomendowanej przez Instytut Badań Edukacyjnych, - dr. Wiktora Dżygóry, zarekomendowanego przez Akademię Wychowania Fizycznego w Katowicach.
" Numer zalecenia: 2432/2009
Mikroskopy serii Delta Optical Genetic Pro są nagrodami dla zwycięzców etapów centralnych Olimpiady Biologicznej www.olimpbiol.uw.edu.pl, sponsorowanej przez Delta Optical.
Oferowany model wyposażono we wbudowaną kamerę o rozdzielczości 3 megapiksele.
Parametry kamery w mikroskopie Genetic Pro
Sensor: Aptina(C)
Przekątna sensora: 1/2.5"
Rozmiar sensora: 5.73x4.30mm
Rozmiar piksela: 2,8 x 2,8 μm
Czułość: 18.8ke-/lus
Dynamika: 73dB
Odstęp sygnału od szumu: 40 dB
Maksymalna rozdzielczość: 2048x1536
Liczba klatek na sekundę (FPS): 30@2048x1536, 30@1024x768 Binning: 1x1,
Czas ekspozycji: 0.1-1000ms
Zakres widmowy: 380 – 650 nm (filtr IR)
Balans bieli: ROI/manualny
Rejestrowane pliki: zdjęcia (JPG, JP2, PNG, WEBP, TFT, TIF, DNG) / filmy (MP4, WMV, AVI)
Interfejs: USB 2.0
Zasilanie: 5VDC/500 mA (z gniazda USB)
minimalne wymagania sprzętowe: Microsoft Windows XP / Vista / 7 /8 /10 (32 & 64 bit), OS X (Mac OS X), Linux, procesor równoważny do Intel Core2 2.8 GHz lub lepszy, pamięć RAM: 2 GB lub-więcej, port USB 2.0 lub lepszy, ekran o przekątnej co najmniej 17" lub większy
Funkcje oprogramowania
- polska wersja językowa
- zapisywanie sekwencji video
- zapisywanie statycznych obrazów
- pomiar odległości
- pomiar kątów
- pomiary pól powierzchni wielokątów
- pomiary promienia okręgu
- wstawianie podziałki do obrazu oglądanego na ekranie (do tego celu należy dokupić szkiełko przedmiotowe mikrometryczne 0,01 mm) możliwość wydruku z podziałką lub bez
Symbol u dostawcy: DO-3410
Regulacja dioptrii: +/- 5D w lewym tubusie
Zastosowanie: Edukacja, Uczelnie Wyższe, Laboratoria, Medycyna, Weterynaria
Korekcja: 160 mm
Źródło oświetlenia: LED
Rozstaw źrenic: 48-75 mm
Obiektywy: 4x 10x 40x 100x
Regulacja ostrości: mikro / makro
Oświetlenie: przechodzące
Stolik mikroskopowy: 142 x 132 mm
Głowica: binokularowa z kamerą
Rewolwer obiektywowy: czteroobiektywowy
Mechanizm przesuwu preparatu: - na dwa preparaty,
- zakres ruchu 75x40 mm
- z noniuszem
Pokrętła regulacji ostrosci: dwustronne, współosiowe
Kondensor: Abbego N.A. 1,25
Technika obserwacji: Jasne pole
klasa optyki: achromatyczna
Możliwość rozbudowy: ciemne pole, kontrast fazowy, polaryzacja
Powiększenia mikroskopu: 40 x 100 x 400 x 1000 x
Powiększenie okularu: 10 x
Pole widzenia okularów: 18 mm
Zasilanie mikroskopu: AC
Działka elementarna ruchu mikro: 4 um
Okres gwarancji: 24 mies.
Wyposażenie
filtr zielony
kabel zasilający
obiektywy achromatyczne 4x, 10x, 40x, 100x
okulary: 10x
olejek imersyjny płyta z oprogramowaniem
pokrowiec przeciwkurzowy